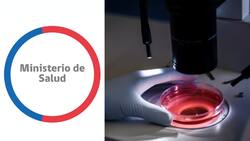
Minsal emite alerta alimentaria por presencia de bacteria en cuatro productos

El Ministerio de Salud (Minsal) decretó la noche de este jueves la extensión de la Alerta Alimentaria vigente desde el pasado martes 24 de diciembre en la Región Metropolitana a otras seis regiones del país.
Todo esto, debido a la detección de un brote de Listeria presente en lotes del queso de cabeza de la marca San Pablo, elaborado por San Pablo Limitada.
- Te podría interesar: Aviso especial de marejadas “anormales” en costas de Chile: ¿Hasta cuándo duran y cuáles serán las zonas afectadas?
Las regiones a las que se extendió la Alerta Alimentaria por Listeria
De acuerdo a lo que determinó la autoridad gubernamental, las regiones a las que extendió la medida son Coquimbo, Valparaíso, O’Higgins, Maule, Los Lagos y Biobío.
El Minsal informó que los lotes del producto que fueron detectados con Listeria son: JC7421R1 con fecha de elaboración 19 de noviembre del 2024 y; AB0541R1 con fecha de elaboración 12 de diciembre del 2024.
La Listeria Monocytogenes, informó la autoridad sanitaria chilena, “es un microorganismo presente en el ambiente y que puede contaminar los alimentos. Es una enfermedad caracterizada generalmente por baja morbilidad y alta mortalidad en su forma invasiva”.
En cuanto a los grupos con más riesgo de ser afectados, se considera a “quienes desarrollan con más frecuencia la forma invasiva de esta enfermedad: gestantes; recién nacidos; pacientes con enfermedades crónicas e inmunodeprimidos (Pacientes Con Cáncer, Trasplantes de Órganos, Hemodiálisis o VIH) y adultos Mayores”.